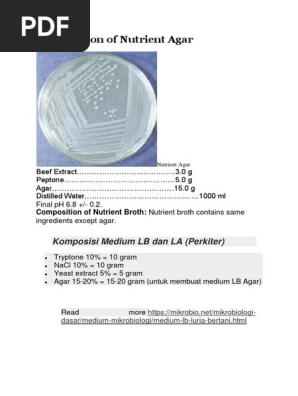

Nutrient Agar Adalah Pdf
Sterilisasi Sterilisasi adalah proses untuk membebaskan suatu benda dari semua mikroorganisme baik yang. Hal ini berguna karena tetap solid bahkan pada suhu relatif tinggi.

Pdf Growth And Cultural Characteristics Of Selected Bacteria On Cowpea Agar Vigna Unguiculata
Side by Side Comparison - Nutrient Agar vs Nutrient Broth dalam Borang Tabular 5.
Nutrient agar adalah pdf. 11022017 Diantara medium yang dibuat dalam percobaan ini yang termasuk dlam medium sintetik adalah medium yang mengandung agar seperti halnya medium nutrient agar yang dignakan untuk mempelajari kebutuhan makanan mikroba. Oleh itu perbezaan utama antara agar nutrien dan sup nutrien adalah agar nutrien mengandungi agar sementara Kaldu nutrien tidak mengandungi agar. Hal ini berguna karena tetap solid bahkan pada suhu relatif tinggi.
UNDERSTANDING THE UNDERSTANDING AND DEFINITION OF GROWTH MEDIA Growth media microorganisms is an ingredient consisting of a mixture of nutrients nutrients used by a microorganism to grow and reproduce in the media. 09042020 Nutrient agar adalah medium yang diklasifikasikan sebagai medium sintetik terstruktur karena tersusun oleh komponen yang pasti jenis dan kuantitasnya. Mengetahui cara penggunaan shaking inkubator dalam pembuatan medium 11.
Animal Origin Declaration for 105450 Nutrient Agar according ISO 6579 ISO 10273 and ISO 21528. Nutrient agar adalah pdf A. Juga bakteri tumbuh di nutrient agar tumbuh di permukaan dan jelas terlihat sebagai koloni kecil.
03 ekstrak daging sapi ekstrak ragi. Product Number Packaging Specification Lot Number. Megetahui penyusun dan pembuatan medium nutrient agar potato dextrose agar dan nutrient broth 10.
Nutrient Agar modified - Liofilchem dokumen pdf dan perpustakaan elektronik unduhan gratis dan pratinjau online. Medium Nutrient Agar NA Komposisi medium Nutrient Agar NA terdiri dari tepung agar 15 gram pepton 10 gram NaCl 5 gram dan beef ekstract 3 gram. Uji yang dilakukan yaitu dengan uji statistik One Way Anova.
Nutrient agar adalah pdf BIOLOGICAL FUNCTIONS OF NUCLEOTIDES. Precursors of DNA and RNA. Activated intermediates in many biosyntheses.
Di pihak lain komposisi nonsintetik tidak diketahui dengan pasti. Hasil penelitian menunjukkan hasil. Media NA yang sudah ditumbuhi koloni bakteri.
Apa itu Nutrien Broth 4. Media ini biasanya mengandung. Nutrient agar adalah medium pertumbuhan mikrobiologi umum digunakan untuk budidaya rutin non-pemilih bakteri.
Nutrient agar dan kaldu nutrisi adalah dua jenis media yang disiapkan dengan cara yang sama dan mengandung komposisi yang kurang lebih sama. 2 Nutrient Agar NA adalah salah satu contoh media yang sering digunakan untuk menumbuhkan dan mengembangbiakkan bakteri. Sementara itu Potato Dextrose Agar PDA merupakan media yang sering digunakan untuk menumbuhkan dan mengembangbiakkan yeast dan kapang.
Apakah Agar Nutrien 3. 06052020 Nutrient Agar NA merupakan medium umum yang digunakan untuk menumbuhkan dan mengisolasi berbagai jenis mikroorganisme dengan beragam sifat yang tidak terlalu rewel non-fastidious growingMedium ini cukup populer dikalangan mikrobiolog karena mudah cara pembuatannya dan bermanfaat sebagai media isolasi kultivasi serta perawatan mikroorganisme. - english-indonesian translations and search engine for english translations.
Data yang dikumpulkan yaitu Jumlah koloni yang tumbuh pada media Nutrient agar dengan penambahan agar 2 25 3 dan 35 setelah diinkubasi pada suhu 37 o C selama 1 x 24 jam. Juga bakteri tumbuh di nutrient agar tumbuh di permukaan dan jelas terlihat sebagai koloni kecil. 12062000 Media Nutrient agar adalah medium pertumbuhan mikrobiologi yang umum digunakan untuk budidaya mikroba.
Gambaran Keseluruhan dan Perbezaan Utama 2. Kedua media digunakan untuk menumbuhkan berbagai macam bakteri tidak rewel di laboratorium. Unduh Versi PDF dari Nutrient Agar vs Nutrient Broth.
2004 Essentials of veterinary bacteriology and mycology sixth Edition. Mengetahui cara penggunaan inkubator dalam pembuatan medium II. Seperti bahan-bahan yang terdapat dalam kaldu nutrient yaitu ekstrak daging dan.
Lalu semua bahan tersebut dilarutkan dengan aquades dalam beaker glass sambil diaduk dan volume digenapkan menjadi 1000 ml. Animal Origin Declaration for 105450 Nutrient agar. Dalam kaldu nutrisi bakteri tumbuh dalam cairan dan dipandang sebagai zat pekat bukan rumpun sejelas.
Jurnal nutrient agar adalah pdf Carter GR and Wise DJ. Nutrient agar adalah medium pertumbuhan mikrobiologi umum digunakan untuk budidaya rutin non-pemilih bakteri. Nucleotside triphosphates especially ATP as the universal.
Microorganisms use nutrients in the media in the form of small molecules assembled to compose their cellular. Dalam kaldu nutrisi bakteri tumbuh dalam cairan dan dipandang sebagai zat pekat bukan rumpun sejelas. Sampel yang digunakan adalah isolat murni Staphylococcus aureus.
HERE are many translated example sentences containing NUTRIENT AGAR. It typically contains massvolume1 05 Peptone - this provides organic nitrogen 03 beef extractyeast extract - the water-soluble content of these contribute vitamins. Nutrient agar Certificates of Analysis.
Medium Nutrient agar merupakan medium umum yang dapat digunakan untuk menumbuhkan dan menghitung populasi berbagai jenis bakteri. Technical Data Sheet. Translations in context of NUTRIENT AGAR.
NA merupakan salah satu media yang umum digunakan dalam prosedur bakteriologi seperti uji biasa. Diatur pH medium yang berkisar antara 68-. Media nutrient agar adalah pdf Streak plates of several bacterial species on nutrient agar plates Nutrient agar is a general purpose medium supporting growth of a wide range of non-fastidious organisms.
Phosphoglycerides S-adenosylmathionine as methyl donor etc. Enter Lot Number Go. Perbedaan utama antara agar nutrien dan kaldu nutrisi adalah penambahan agar.
Warna dari medium ini adalah kuning keemasan dan cenderung jernih. 07072015 Pembuatan Nutrient Agar. Timbang komponen medium dengan menggunakan timbangan analitis untuk volume yang diinginkan sesuai.

Jenis Jenis Media Pertumbuhan Laboratorium Mikrobiologi Standar

Sayyidul Istighfar Reading Al Quran Islamic Quotes Islam
Http Journal Poltekkesdepkes Sby Ac Id Index Php Ankes Article Download 1207 776

Komentar
Posting Komentar